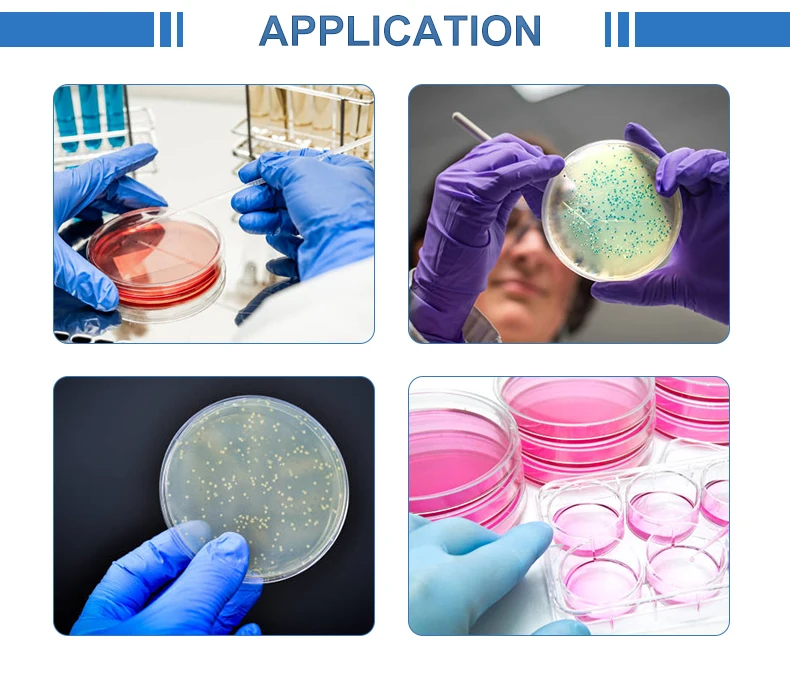
6-Petri dishapplication
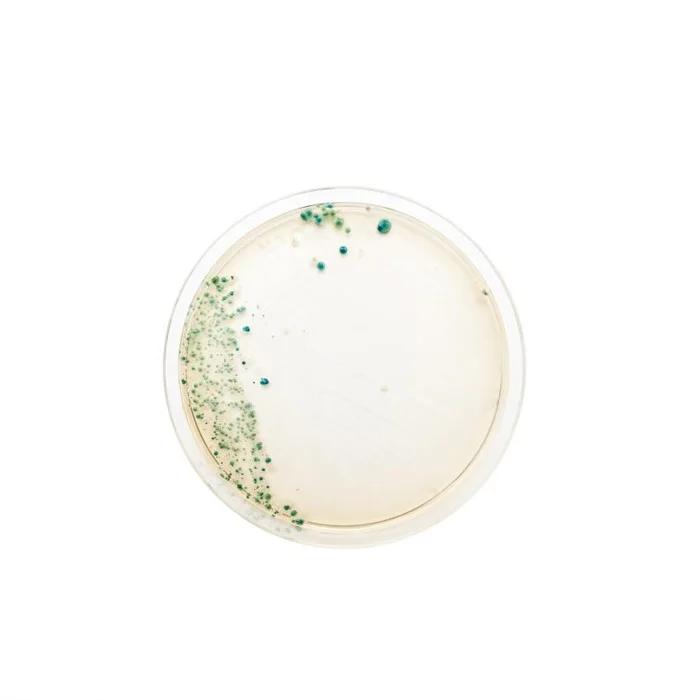
GPD0515-052 laboratory equipment Transparent Petri Dishes

GPD0515 052 laboratory equipment Transparent Petri Dishes
- Category: >>>
- Supplier: Yangzhou Goldenwell Medical Devices Factory
Share on (278820814):
Product Overview
Description
GPD0515-052 laboratory equipment Transparent Petri Dishes
1. Dish with high transparency, ideal container for bacterial culture, also can be used in sample separation, pre-treatment, storage & etc;
2. uniform wall thickness ensures distortion-free bottom;
3. Lid ridges are designed for optimal gas exchange
4. All dishes are clean & optional for EO. Gas sterilization;
5. Dishes are packed in medical style plastic bags & with lot number for quality tracing;
Application:
*chemical industry
*petrochemical industry
*biochemical pharmaceuticals
*laboratory and eduction
Product name | Standard | Amount/ctn |
Petri Dish | 35mm | 10pcs/bag,50bag/ctn |
60mm | 10pcs/bag,80bag/ctn | |
70mm | 10pcs/bag,100bag/ctn | |
90mm | 10pcs/bag,50bag/ctn |
1, Effective communication and prompt response.
2, High quality products support you to win your market.
3, Commit to new and innovative technology to meet latest market demand.
4, Develop new and unique products with you.
5, Any suggestions for our products and price, etc. are welcomed.

1. Why our price is the lowest?
Because we are a factory
2, How about the lead time?
About 30 working days after receiving the payment and confirming all the artworks, exactly lead time upon the quantity of your order and the packaging you required.
3, Can our private logo / label be printed on the packaging?
Yes, your own private logo/ label can be printed on the packaging upon your legal authorization, we do OEM service for many years.
4.How can i get some samples?
1. We may provide some samples of free, the postage will be paid by yourself. The post charges will be deducted from payment for goods after we bargained on the order .
2. You can give us your collect account (just like DHL, UPS etc) and detail contact information. Then you can pay the freight direct to your local carrier company.
5. What is the best price you can offer?
We always working hard to satisfy our customer, from the quality until the price, as we do understand the market situation. So, please don't hesitate to send your inquiry for us to give you our best price.
6.Why choose us?
1.We are the leading Lab products manufacturer in China
2.Alibaba verified factory, passed CE ISO
3.Best service and quality with competitive price
We Recommend
New Arrivals
New products from manufacturers at wholesale prices